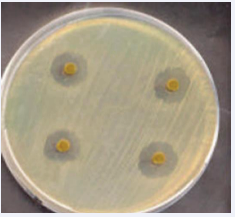

A Chronic Prostatitis Case Report with Frequent Re Acutization: Factors Involved and Examples of Remedy
- 1. IMA academy, Applied Pharmacologist, Clinical Hospital Pharmacist, Italy
- 2. Department of Medical & Health Sciences for Woman, Peoples University of Medical and Health Sciences for Women, Pakistan
- 3. Cabianca L Medical laboratory Turin, Citta della salute, Italy
- 4. Department of Hematology Oncology, University of Aden, Yemen
- 5. IMA Academy President, Italy
Abstract
Even if hemorroides, anal fissure and prostatitis are different pathological condition the anatomical and vascular and lymphogenous connection make possible the interconnession. Aim of this work is to analyze the effect played by this conditions in the prostatic pathology. An specific case report is submitted to the reseacher in order to clarify some facts.
It is of interest to observe that some common measure can alleviate the pelvic pain due by this kinds of conditions or to stop a specific vicious circle . This work is produced under An applied pharmacology and clinical pharmacist point of view and more focused on the mechanism of action of some remedy then versus the registered indication.
Keywords
• Prostatistis ;Aemorroides; Anal Fissure; Lymphogenous Spread; Constipation; Rectal Bacteria; Prostaglandin PGE; Prostatic Cancer; Saccaromyces Cerevisiae Extract; Topic Treatements; Sitz Bath; Sexual Activity
Citation
Luisetto M, Mashori GR, Hamid AG, Cabianca L, Yurevich LO (2025) A Chronic Prostatitis Case Report with Frequent Re-Acutization: Factors Involved and Examples of Remedy. J Urol Res 12(1): 1161.
INTRODUCTION
Prostatitis can be divided in bacterical and non bacterical, acute and chronicized, inflammatory
From Medscape: Chronic bacterial prostatitis: “Chronic bacterial prostatitis (CBP) is most often caused by Escherichia coli or other gram-negative Enterobacteriaceae, and typically affects men 36 to 50 years of age.”
Various risk factor is generally involved in this pathology and the rate of failure of the therapy or recurrency Need a deeply evaluation of the situation that can aggravate. Anal fixture, hemorroides, Constipation, behaviour habits, sexual activity level can influence the situation
Prolonged sitting position in a rigid chair can produce prostate inflamation and the GUT microbiota can Be involved.
From S. Adam Ramin:” Men who do not ejaculate regularly tend to accumulate semen, prostate secretions, and sperm in the genital tract. Stasis of these secretions can cause the accumulation of bacteria leading to prostate infection. Other risk factors for bacterial prostatitis: lifestyle, Prolonged sitting, over a long time. The weight of the body on the perineum in a seated position often leads to prostatic irritation and translocation of bacteria from the rectum into the prostate. In people with chronic bowel health conditions, naturally occurring bacteria in the large intestine may translocate from the bowel wall into the prostate, causing bacterial prostatitis. People with chronic diarrhoea, constipation, diverticulitis, or inflammatory bowel disease, are more likely to develop some prostate infections.”
“The actual routes of prostatic infection are unknown in most cases: the ascending urethral infection is a known route because of the frequency of previous gonococcal prostatitis, as the finding of identical organisms in prostatic fluid and vaginal culture in many couples. Intraprostatic urinary reflux has been demonstrated in human cadavers and may play a role. Other possible routes of infection include the hematogenous spread, migration of rectal bacteria via direct extension, and lymphogenous spread. ”AFP Australian family physicians Prostatitis April 2013
Prostatitis Diagnosis and treatment
“Chronic bacterial prostatitis may result from ascending urethral infection, lymphogenous spread of rectal bacteria, hematogenous spread of bacteria from a remote source, undertreated acute bacterial prostatitis ABP or recurrent urinary tract infection with prostatic reflux.” From NIH Anatomy, Abdomen and Pelvis, Prostate Omesh Singh; Srinivasa Rao Bolla. July 17, 2023.
“The inferior vesical artery is the major blood supply for the prostate, and it also receives blood supply from the middle rectal and internal pudendal arteries.” Veins around the prostate form the prostatic plexus which drains into internal iliac veins.
The concept that hemorrhoids lead to prostatic venous congestion is put forward. The urethral discharge at defecation seems to be the result of “milking” of the congested prostate by the hard stools “A pathogenic theory involving a correlation between altered anal canal microflora, local inflammation, and muscular dyssynergia is proposed through an wider review of the literature.
The varicose vein theory, the vascular hyperplasia theory, and the concept of a sliding anal lining. These phenomena determine changes in the connective tissue (linked to the inflammation), including loss of organization, a muscular hypertrophy, fragmentation of the anal subepithelial muscle and the elastin component, vascular changes, including abnormal venous dilatation and with vascular thrombosis.
Studies have reported a possible involvement of gut microbiota in the gut motility alteration. Dysbiosis seems to represent the leading cause of bowel mucosa inflammation in any intestinal district. The alteration of the gut microbiome GM in the anorectal district could be responsible for haemorrhoids and other anorectal disorders.
There is a dysregulation of the vascular tone with hyper- perfusion of the hemorrhoidal plexus in patients with the haemorrhoids. Unfortunately, hyperperfusion does not translate into an hyperoxygenation.
Studies showed inflammatory cells and newly formed micro vessels of hemorrhoidal tissue HT. Hypoxia could be considered the main responsibility of the inflammatory state.
The pathophysiology is multifactorial, including sliding anal cushion, hyperperfusion of haemorrhoid plexus, the vascular abnormality, tissue inflammation and internal rectal prolapse.
Haemorrhoids are strictly linked to another anorectal conditions, like anal itching, fissures whit an involvement of the smooth musculature of the internal anal sphincter. All anorectal disorders could be considered the direct consequence of the constipation.”
According Cleveland clinic: Hemorrhoids, or piles, are a common issue. These swollen veins inside of your rectum or outside of your anus can cause pain, anal itching and rectal bleeding. Anal fissures: according Mayo clinic an anal fissure is a small tear in the thin, moist tissue that lines the anus. And According NIH: Prostatitis is a frequently painful condition that involves inflammation of the prostate and sometimes the areas around the prostate.
Clinical laboratory and instrumental studies in patients with chronic prostatitis and haemorrhoids January 2016 Andrology and Genital Surgery. “The association of the development of prostatitis with chronic hemorrhoids CE is attributed to the close arrangement and anatomically common lymphatic and venous formation of these organs. Analysis of the data of 140 patients with chronic prostatitis CP and hemorrhoids with frequent exacerbations showed that more than 2 signs of chronic prostatitis were recorded in 86.9 % of the patients with chronic hemorrhoids” (Figure 1).
Figure 1 : The lymphatic drainage of pelvis.
“BPH commonly occurs in older men with chronic prostatitis. Although BPH is frequently accompanied by inflammation, it is unclear whether inflammation underlies prostate enlargement. We reported that hypoxia-inducible factor 1α (HIF-1α), which is known to be induced by the proinflammatory cytokines, is involved in testosterone induced prostate hyperplasia. And related the alcohol intake and prostatitis congestion: molecular medicine reports
The role of ethanol in the pathogenesis of non-bacterial prostatitis Feng Liu, Lintao Liu, Zhong Wang, Lin Chen ,Jianjun Yu, Xiaolin Xu 2019 https://doi.org/10.3892/ mmr.2019.9991 (Figure 2).
Figure 2 : From medascape.com
“When the prostates of ethanol-exposed EE rats with prostatitis were removed, the prostates were damaged, and enlarged with local congestion of glands and edema. H&E staining revealed that blood vessels were outstretched and glands were damaged in group D. These results indicated that there was an inflammation in rats treated with ethanol. Significant glandular changes, severe inflammatory infiltration hyperplasia of fibrous tissue was observed in the prostates of group D. The expression of TNF-α, iNOS in group D rats were the highest, the expression of T-AOC was much lower in group D group compared with group A. To further analyze inflammation levels, the mRNA expression levels of α1a-AR, α1b-AR, and α1d-AR were investigated via RT-qPCR. α1a-AR expression was highest in the groups D, which indicated that α1a-AR may be the most important mRNA subtype in these rats.”
Material and methods with an observational point of view various relevant literature and patents are reported related the topic of investigation.
A specific case report is submitted to the researcher.
After this a global conclusion is reported.
RESULTS
Form literature
“We analyzed the incidence of anal disease in patients with nonbacterial prostatitis NBP or with prostatitis like syndrome, and evaluated the clinical efficacy. The complicated rate of anal disease in these patients was 29.7% (31.8% for NBP and 28.1% for PLS), and the overall incidence of active anal disease was 15.4% (16.2% for NBP and 14.8% for PLS), it yielded a significantly higher complicated rate than other urological disease (p less than 0.01). The most common type of anal disease AD was hemorrhoids. The clinical cure rate for anal disease in NBP patients was 71.4%, and in PLS patients was 58.2%. The high incidence of hemorrhoids was in these patients by clinico-statistical observation suggests that the development of anal disease AD may be etiologically correlated with NBP and PLS. Kampo treatment was useful in the treatment of prostatitis complicated by anal disease, especially when combined with anti-hemorrhoidal suppositories against active anal disease in PLS patients (p less than 0.05) [1]” (Figure 3).
Figure 3 : Prostate and rectum From Jaypee Digital
“The diagnosis “prostatitis” is frequently a makeshift. It not uncommonly occasions long-term antibacterial chemotherapeutic measures which are often ineffective. The symptoms of “prostatitis may be caused by an anogenital syndrome AS. This diagnosis can only be made on the basis of meticulous urological and proctological investigations. They frequently obscure the proctological cause of such symptoms (like haemorrhoids) [2]”.
“Intestinal bacteria IB can enter the prostate through the urinary tract or travel through the bloodstream, resulting in infections that contribute to inflammatory conditions like bacterial prostatitis and chronic bacterial prostatitis CBP, ultimately increasing the risk of BPH and PCa [3]”.
“The use of a Saccharomyces cerevisiae-based ointment for haemorrhoids has been quite diffuse in the proctologist community. A study reported the beneficial effects of S. cerevisiae against Clostridium difficile CD infections. In a study on pigs, S. cerevisiae SC was able to reduce the translocation of enterotoxigenic E coli, strengthening mucosal immunity. Gaziano et al. proposed S. cerevisiae as a possible treatment of vulvovaginal candidiasis and bacterial vaginosis, thanks to its immunobiotic properties. They demonstrated that the yeast has a major role in reducing the colonization of C. albicans and/or G. aginalis on human mucosal surfaces and enhancing the antimicrobial effect of the standard therapeutic approaches (Figure 4).
Figure 4 : From Teach me surgery
Dietary supplementation of S. cerevisiae significantly decreases enteric methane production : increasing of O2 utilization to allow for a more favourable environment for anaerobic fermentation, which in turn leads to higher volatile fatty acids FA production and lower pH, which restrains the growth of methanogens and protozoa, induction of a shift in fermentation pattern toward propionogenesis, which compete with methanogens for the free H2 within the system, and increasing of acetogenic bacteria growth BG, which use H2 to produce acetate, which serves as another alternative sink for the free H2 in the system. Deepened the role of the mycobiota in the GI tract. Patients with Crohn’s disease CD tend to have much higher levels of the fungus Candida tropicalis compared to their healthy family members, as well as two bacteria, E. coli and Serratia marcescens SM. These three organisms work together to form robust biofilms capable of exacerbating intestinal inflammation. Candida colonization has been also highlighted in patients suffering from ulcerative colitis UC, gastric, duodenal ulcers. Candida colonization seems to have a role in delaying reparative processes, while inflammation promotes its growth. These effects may create a vicious cycle in which low-level inflammation promotes fungal colonization, and fungal colonization promotes further inflammation. IBD and GI Candida colonization are associated with elevated levels of the proinflammatory cytokine IL-17. Effects on IL 17 levels may underlie the ability of Candida colonization to enhance inflammation [4]”.
“The effect of S. boulardii SB on experimental colitis induced by the single oral administration of 1 mg/kg of clindamycin in the Syrian hamster was studied. Oral administration of S. boulardii for 13 days, starting 3 days prior to the administration of clindamycin, significantly reduced the mortality rate and inhibited the growth of C. difficile CD in the caecum and colon. There was a marked improvement in the sub-mucosa and mucosa which showed major inflammatory lesions when clindamycin was administered alone [5]”.
“Research has demonstrated that the microbiome can affect both prostatitis and the inflammation of the prostate that is linked to prostate cancer PC. Our investigation established the genetic links between nine gut microorganisms and prostatitis, which may offer fresh perspectives and a theoretical framework for the future prevention and management of the prostatitis [6]”.
“Short-chain fatty acids SCFA, metabolites of the intestinal microbiota, protect the integrity of the intestinal barrier, regulate immunity, and inhibit inflammation.
Dysregulation of the gut microbiota significantly reduces the SCFA content in faeces and impairs the integrity of the gut barrier, leading to the translocation of bacteria and bacterial components like as lipopolysaccharide, mediating the development of prostate inflammation through microbe-associated molecular patterns MAMP.
In healthy people: the metabolites derived from intestinal microorganisms, butyrate, upregulate the expression of claudin-1, occludin, and the zonula occludens 1 to enhance tight junctions and protect intestinal barrier function. Butyrate binds to GPR109A and regulates the secretion of IL-10 and IL-17 by Treg cells to inhibit the inflammation.
Instead in “gut dysbiosis”, the n. of microbes producing SCFAs decreases, and the n. of harmful bacteria increases, with in damage to the intestinal barrier IB and “leaky gut” syndrome, which leads to the translocation of bacteria and bacterial component lipopolysaccharide and causes systemic inflammation.
Bacteria and LPS bind to TLRs as MAMPs, upregulate the expression of NF-κB, and activate NLRP3 inflammasome.
LPS and various inflammatory factors travel through the circulation to the prostate and cause an inflammatory response IR in the prostate. IECs, intestinal epithelial cells; ZO-1, zonula occludens 1; MAMPs, microbial-associated molecular patterns [7]”.
The saccaromyces cerevisiae extract is employed as topical to treat hemorroides: because it stimulate the cellular respiration inducing fibroblast activation, connective cell tissue , and collagene production.
“The active involvement of skin fibroblast SF in wound healing and synthesis of extracellular matrix makes skin fibroblast an essential model in the study of ageing and anti-ageing mechanism.”
“The isolate showed better anti-bacterial activity against gram negative (-) bacteria than gram (+) positive. The isolate showed strong antioxidant activity, reducing power, nitric oxide and hydroxyl radical scavenging activity, significant brine shrimp cytotoxicity and acute toxicity and metal ion chelating activity. S. cerevisiae and S. boulardii are clinically proven yeasts being used as a human probiotic and has shown to positively influence host’s health by antimicrobial effect, inactivation of bacterial toxins, trophic effects, immuno-modulatory effects, anti inflammatory effects, cell restitution and maintenance of epithelial barrier EB integrity (Figure 5).
Figure 5 : Morphology of the prostate gland evaluated by hematoxylin and eosin staining. Histological observation of prostate in (A) normal rats, (B) ethanol-drinking rats, (C) chronic non-bacterial prostatitis rats and (D) ethanol-drinking chronic non-bacterial prostatitis rats. Magnification, ×10.
“Saccharomyces cerevisiae SC yeast exhibits antibacterial activity against E. coli, Pseudomonas sp. Salmonella sp., Staphylococcus aureus SA, and Vibrio cholera. This yeast strain has antimicrobial activity against other pathogenic bacteria species, yeasts, and molds” “drugs showing inhibition of prostate smooth muscle contraction are a mainstay in medical treatment of BPH-related symptoms. Available medications include α1-adrenoceptor antag. as the first-line option and the phosphodiesterase 5 inhibitor tadalafil. Both were proposed to improve the symptoms by relaxation of prostate smooth muscle [8]”.
“Antagonism of microorganisms by yeasts has been attributed primarily to competition for nutrients, pH changes in the medium as a result of growth-coupled ion exchange or organic acid production, production of high concentrations of etoh, secretion of antibacterial compounds and release of antimicrobial compounds like as killer toxins or “mycocins [9]”.
“Serum total PSA values in the constipated patients before treatment were significantly higher than those in control group (2.29±1.29 ng/mL vs 1.28±0.86 ng/mL, P<0.0001) [10]”.
“The diagnosis of CP/CPPS was associated with previously diagnosed IBS. Urologists should be aware of the association between CP/CPPS and the IBS when treating patients [11]”.
“Prostate cancer PC risk was inversely associated with total dietary fiber intake (HR of quartile 4 vs. quartile 1 = 0.47; 95% CI: 0.27, 0.81; P = 0.001), insoluble (HR = 0.46; 95% CI: 0.27, 0.78; P = 0.001), and legume (HR = 0.55; 95% CI: 0.32, 0.95;P = 0.04) fiber intakes [12]”.
What is a donut pillow? is a round shape pillow with a hole in the centre. They can be made of different materials like memory foam, gel and natural latex material, usually portable, that can be used for treating various conditions that cause tailbone pain.
Common health conditions where donut pillow is recommended are: Haemorrhoid (piles), Ulcers Prostatitis related recovery or Pregnancy and some Back pain
They are also useful as a post-operative measure POM for relieving tailbone pain. These pillows help in maintaining a proper posture and relieve pressure from the tailbone while sitting.
It is important to use a good quality donut pillow as per your size, and intensity of symptoms to get significant relief in the haemorrhoid pain.
Ring Pillow, Bed Pain Prevention Cushion Portable for Prostatitis for Hemorrhoids for Patients:
From Cleveland Clinic website: Sitz bath for hemorrhoids
Hemorrhoids are swollen veins located in your lower rectum and anus. They occur for many reasons, including constipation, pregnancy and the childbirth. Sitz baths can help reduce pain and swelling caused by hemorrhoids. If you’ve recently had hemorrhoids removed, sitz baths can also help with any discomfort you may feel after a surgery.
Prostatitis (from Canadian C. society):
“Supportive therapy may be given to relieve pain and discomfort. Your doctor may prescribe medicines to relieve fever and pain or to soften your stool (poop). You may be given fluids orally or through a needle in a vein to help prevent dehydration. The healthcare team HT may also recommend relaxation exercises for the muscles of the pelvic floor and warm baths that cover just the hips and buttocks (sitz bath).”
“180 patients were enrolled, mean age 52 ± 14.97. Nonbacterial prostatitis NBP (85 %). All patients completed visits 1 and 2. All patients were treated with beclomethasone dipropionate suppositories, 136/180 also with Serenoa repens extract. Antibiotics were rarely required.162/180 patients presented clinically significant improvements and terminated the treatment (Figure 6).
Figure 6 : Prostatic inflammation caused by gut dysbiosis
Mean change vs. baseline in voiding frequency: −3.55 ± 2.70 n/day in patients taking only BDP and −3.68 ± 2.81 n/day in those taking both BDP and SR (P<.0001 in both groups). Uroflowmetry improved significantly; change from baseline 3.26 ± 5.35 ml/s in BDP only group and 5.61 ± 7.32 ml/s in BDP + SR group (P = 0.0002 for BDP, P<.0001 for BDP + SR). Urine stream US normal in 35 % of patients at visit 1 and 57.22 % of patients at visit 2. Mean change in perineal pain, on 0–10 VAS, −0.66 ± 2.24 for BDP only group (P = 0.0699) and −1.37 ± 2.40 for BDP + SR group (P<.0001). IPSS increased at visit 2. No adverse events AE were reported [13]”.
“Bosexil® is a vegetal extract derived from the resin of Boswellia serrata BS, a plant native to India. Boswellic acids(BAs)already showed anti-inflammatory and antioxidant properties in a variety of inflammatory diseases, including rheumatoid arthritis, osteoarthritis, asthma, whose physio pathological pathways could be shared with those of chronic prostatitis CP .
FenolmicinaP3®, a polyphenolic extract derived from beehive propolis, demonstrated anti-inflammatory, anti microbial and antioxidant properties in several pre-clinical reports PCR. The aim of our work was to test the efficacy and safety of the association of Bosexil® and FenolmicinaP3® in relieving prostatitis-like symptoms in an adult male, prospective cohort. The association of Boswellia resin extract BRE and propolis derived polyphenols can reduce Genito urinary pain and then improve quality of life of men affected by bothersome prostatitis - like symptoms [14]”.
“The prostate gland produces fluid for semen and infrequent ejaculation may cause the ducts to become clogged and with secretions.”
Signs and symptoms of ejaculatory duct obstruction:
Low volume of ejaculate (less than 1.5 milliliters). Low sperm output and/or low sperm count.
Pain during or after sex. Pain in your prostate, Blood in your semen ,Blood in your urine since also Infertility.
Between the Causes of EDO:
Genes, like those involved in cystic fibrosis, the ducts may be absent (atresia) or atrophic (collapsed).
Scar tissue from previous pelvic surgery or damage to the urethra, called, Cysts.
Previous frequent UTIs, chronic Prostatitis, Epididymitis, the cord that transports sperm located at the back of each testis).
“Ejaculating more than 20 times per month reduced prostate cancer PC risk by about 20% compared to ejaculating only four to seven times per month, for both men in their 20s and 40s [15]”.
“Overall, men who reported ejaculating at least once a week were less likely to have moderate to severe (Intern, Prostate Symptom Score IPSS greater than 7) symptoms than men reporting no ejaculations (odds ratio 0.62, 95% confidence interval 0.51 to 0.75 [16]”.
“This condition has been designated as a chronic congestion of the prostate, aseptic prostatitis, and even non-specific prostatitis NSP. Toxic hyperplasia of the prostate is a more descriptive term inasmuch as it designates the increase amount of secretion and also the toxic effect (TE) produced by the absorption of this excessive secretion. [17]”.
“Human seminal fluid contains various prostaglandins: PGE (PGE1 and PGE2), PGF2α, and their specific 19-hydroxy derivatives, 18,19-dehydro derivatives of PGE1 and PGE2” [18]”. “2 main groups of molecules, the prostaglandins (PG) and the cytokines, have been discovered and play a major role in inflammatory processes. The activation of prostaglandins PGE2, PGD2 and PGI2 results in prominent symptoms during cardiovascular CV and rheumatoid diseases [19]”.
“PGE2 is a bioactive lipid that elicits a wide range of biological effects associated with inflammation and cancer. PGE2 exerts various effects on cell proliferation, apoptosis, angiogenesis, inflammation and immune surveillance [20]”.
“There is evidence to suggest that PGE2 plays an important role in the regulation of vascular smooth VS muscle tone [21]”.
“Activation of the PGE2 -EP2 or -EP4 receptor signal induces vasodilatation in mural cells, resulting in increased local blood flow BF and hyper-permeability [22]”
“We evaluated the association between chronic prostatitis syndrome CPS, varicocele and hemorrhoids as manifestations of a pelvic venous disease. Our retrospective study was based upon 2,554 patients treated in two general urology clinics over the past 10 years. We have assessed the incidence of CPS among urological patients. We found 483 patients with CPS, representing 18.9% of the total n. of visits at the outpatient clinic. In this group the % of varicocele and hemorrhoids was 14.69 and 8.48%, whereas in a control group these figures were 5.02 and 5.84%, respectively (p < 0.001 and 0.1054) [23]” (Figure 7).
Figure 7 : Chromatogram of gel filtration for antibacterial peptides from Saccharomyces cerevisiae by ÄKTA Pure 25 using Superdex 200 10/300 GL. (A) Inhibition zones of E. coli by peak1, (B) non-inhibition zone of E. coli by peak2 and peak3.
“We analyzed the incidence of anal disease in patients with nonbacterial prostatitis (NBP) or with prostatitis-like syndrome (PLS), and evaluated the clinical efficacy. The complicated rate of anal disease AD in these patients was 29.7% (31.8% for NBP and 28.1% for PLS), and the overall incidence of active anal disease was 15.4% (16.2% for NBP and 14.8% for PLS), it yielded a significantly higher complicated rate than the other urological disease (p less than 0.01). The most common type of anal disease was hemorrhoids, especially piles [24]”.
“The current literature has shown that cancerous prostate tissue contains bacterial DNA, unlike healthy prostate tissue.
Many studies have indicated that the microbiota can influence prostate tumorigenesis through direct or indirect mechanisms.
Under direct mechanisms, Prostate cancer is associated with chronic inflammatory urinary tract conditions like as: Chronic prostatitis and BPH. Under indirect mechanisms, the gut microbiota GM is said to influence metabolic processes and systemic inflammation that tend to trigger prostate tumorigenesis [25]”.
“The mechanisms of action of Serenoa repens SR include alterations in cholesterol metabolism, antiestrogenic and antiandrogenic effects, anti-inflammatory effects, pro apoptotic properties, and relaxation of smooth muscles in the prostate and detrusor [26]”.
“Tamsulosin is a subtype-selective alpha(1A)- and alpha (1D)-adrenoceptor antagonist. alpha(1)-Receptors predominate in the prostate gland, prostatic capsule PC , prostatic urethra and bladder, and the relaxation of prostate and bladder smooth muscles BSM is associated with improved maximal urine flow (Q(max)) and alleviation of LUTS in patients with BPH [27]”.
According https://www.nhs.uk/medicines/ tamsulosin/about-tamsulosin/ (Figure 8-11).
Figure 8 : From Cleveland Clinic website
Figure 9 : Regulation of T cell subsets by PGE2. PGE2 activates the differentiation of Th1 cells by decreasing the levels of cAMP; PGE2 can enhance the IL-4/IFN-γ ratio in CD4+ T cell culture and regulates CD4+ T cell polarization towards Th2 cells; PGE2 promotes the differentiation of naïve CD4+ T cells into Th17 cells via the EP2 or EP4 receptor and cAMP pathway; PGE2 promote Tfh differentiation; PGE2 suppresses the EP/cAMP/PKA pathway ,inhibits Treg cell differentiation; PGE2 inhibits the antiviral activity of CTLs and the survival of patients receiving cancer immunotherapy
Figure 10 : Antibacterial activity of Saccharomyces boulardii against four pathogenic bacteria (Enteropathogenic Escherichia coli, Salmonella, Staphylococcus aureus and Clostridium perfringens.
Figure 11 : Transrectal Prostatic Pchography: Seminal Vescicle Important Dilatation
“The main side effects of tamsulosin are feeling dizzy and problems when ejaculating (such as little or no semen).”
Painful Ejaculation - An Ignored Symptom
“Ejaculatory duct obstruction: It is a rare condition that can be caused by several pathologies such as ejaculatory duct malformations, midline prostatic cysts, fibroses due to prostatitis or seminal vesiculitis, seminal vesicle stones, or scarring after endoscopic manipulation”
Justia Patents:
Anal, Rectal ,Suppositories U.S. Patent Application for Method, composition, and delivery mode for treatment of prostatitis and other urogenital infections using a probiotic rectal suppository Patent Application (Application #20080274162)
“Method, composition, and delivery mode for treatment of prostatitis and other urogenital infections using a probiotic rectal suppository; 2007
This invention is a probiotic composition using the delivery mode of a rectal suppository RS for the treatment and relief of symptoms of urogenital infections UI including prostatitis. This invention is unique in both mode of delivery and in enabling the treatment of such urogenital infections as prostatitis. The present invention discloses compositions, methodologies, and delivery mode for the utilization of probiotic organisms in therapeutic compositions for treatment and relief from the symptoms of urogenital infections UI by maintaining and restoring normal flora in humans. The composition includes one or more bacteria selected from the genus Lactobacillus. The invention involves the utilization of one or more species or strains of Lactobacillus producing bacteria for the control of urinary tract bacteria UTB and pathogens, including antibiotic-resistant urinary tract pathogens, and their associated diseases by both a reduction in the rate of colonization of the infection and pathogens. The method for treatment and relief from symptoms includes administration via a rectal suppository RS with a safe and effective amount of the composition. The delivery mode for administering the probiotic is via a rectal suppository RS. The delivery through the rectum provides an optimum method of transmission of the treatment [28]”.
“In this single-center, prospective, randomized, open label, phase-III study, patients with indication to ThuLEP were enrolled (Dec2019–Feb2021-Institutional ethics committee STS CE Lazio approval no.1/N-726— ClinicalTrials.gov NCT05130918). The report conformed to CONSORT 2010 guidelines. Eligible patients were 1:1 randomized. Group A: patients who were administered Phenolmicin P3 and Bosexil suppositories twice a day for 5 days, then once a day for other 10 days; Group B: patients who did not receive Phenolmicin P3 and Bosexil (“controls”). Study endpoints were evaluated at 15 and 30 days postoperation. Primary endpoint included evaluation of effects of the suppository on irritative symptoms IS by administering IPSS + QoL questionnaire. Secondary endpoint included evaluation of effects on urinary tract infections by performance of urinalysis with urine culture. The present randomized trial investigated the efficacy of Phenolmicin P3 and Bosexil supp. in control of irritative symptoms and prevention of lower urinary tract infections LUTI in patients undergoing ThuLEP. IPSS improvement 30-days postoperation was more pronounced in patients who received Phenolmicin P3 and Bosexil. Lower rate of positive (+) urine culture favoured Phenolmicin P3 and Bosexil suppository group 15-days postoperatively [29]”.
CASE REPORT
A case of adult, 120 kg, age 60 years old, diabetes type II controlled, history of recurrent prostatitis (more than 20 year, every 3 months but also more frequent).
Normal flux if not congested, light uretral restriction confirmed by retrograd uretroghraphy, abnormal urinary fluxumetry. Ecographic prostate: microcalcification present, and seminal vesicle volume increased.
Urologic inspection: normal volume. Positive seminal liquid for candida, Psa negative. Many times, sitting position during the days, reduced physical activity, constipation. Great caffeine intake daily, no smoking
Worsening condition: Alcohol intake greatly agravate, spicie use aggravate
Starting episode
Especially after a constipation episode especially or after prolonged sitting position on rigid sitting.
Hemorrides present, anal fissuration, history of low anal bleeding.
Ciproxin: good efficacy if prolonged 5-7-10 gg, Clarithromycin good but relapses
Sulfamidics – trimetroprim good efficacy also in preventing, Sporanox good efficacy
Tamsulosin good to reduce bladder iperactivity, Saccaromices cerevisiaee extract supp good to stop some episode.
Fenolmicin P3 and Boisexil supp., good efficacy if prolonged 3-5 days, Sereno repens efficacy in reducing prostate pain and increase little the urinary flcus, Urtica dioica: efficacy
Quality of life worsened highly during episode. Number of episode :every mouth, but after ciproxin prolonged (7 10 days) every 6 month.
DISCUSSION
Chronic bacterial prostatitis (CBP) may result from ascending urethral infection, lymphogenous spread of rectal bacteria (Dickinson).
Even if hemorroides, anal fissure and prostatitis are different pathological condition the anatomical and vascular connection make possible the interconnession.
The location of hemorrhoids is close to the rectum and prostate.
Related the Chronic bacterial prostatitis: Other possible routes of infection include hematogenous spread, migration of rectal bacteria via direct extension, and lymphogenous spread.
The hemorroidary venous plexus communicate with the bladder prostatic plexus and with the peri- neo superficial veins.
Pelvic vascular diseases cause hemorrhoids and prostatitis, there are various connections between pelvic blood vessels with a certain mutual influence and interaction between them. Topical physical therapy can be used to relieve symptoms in both these conditions.
A patient with hemorrhoids can affect the prostate through the pelvic veins system, resulting in a prostatitis.
If the patient treats hemorrhoids, the symptoms of prostatitis can also be relieved by drugs, this can be considered a specific connection between this condition.
Hemorrhoids can also be caused by prostatitis: this because prostatitis is caused by some symptoms of urination, such as insufficiency of urination and excess urination: the patient needs to increase abdominal pressure every time they urinate.
Abdominal pressure increases due to prolonged abdominal pressure. After the increase in abdominal pressure, blood flow obstruction will occur, resulting in rectal vein congestion, which will expand to form hemorrhoids.
One cause of hemorrhoids is constipation and large amounts of stool in the colon.
Palumbo V. D. et al “According to the current accepted physio pathological mechanism of hemorrhoidal disease, increased intraabdominal pressure AP (due to constipation, diarrhoea, pregnancy, or obstructed defecation) and arterial hyperperfusion of the hemorrhoidal plexus represents the most important initiation points. The subsequent reduction of venous return VR during defecation and stagnation of blood inside the dilated plexus favour inflammation and its epiphenomena (oedema, ischemia and thrombosis). Inflammation is responsible of the impaired quality of collagen and relaxation of the supporting muscles of the internal hemorrhoidal plexus IEP. These events lead to sliding of the anal cushions that is responsible for all symptoms experienced in haemorrhoids.”
CP/CPPS (Chronic prostatitis/chronic pelvic pain syndrome) was associated with previously diagnosed IBS.
Constipation increases serum PSA levels in men.
Prolonged sitting position, over a long period can aggravate: The weight of the body on the perineum in a seated position often leads to prostatic irritation and translocation of bacteria from the rectum into the prostate
According Md Fakruddin et al “S. cerevisiae and S. boulardii are clinically proven yeasts being used as a human probiotic and has shown to positively influence host’s health by antimicrobial effect, nutritional effect, inactivation of bacterial toxins, quorum sensing, trophic effects, immuno-modulatory effects, anti-inflammatory effects, cell restitution and maintenance of epithelial barrier integrity .”
Saccaromyces Boulardii is linked to Cerevisiae but it is different in taxonomic, metabolic and genetic.
Related the case report submitted it is of interest that the episode generally start trough a constipation episode added to a prolonged sitting position with a weak hemorrhoidal involvement, then a cystitis -prostatic acute event.
The episode reported in this case report was controlled well using antibiotics like ciproxin or claritromicin and with the use of Sporanox (reduce intense itching, diabetes favour micosis ). The greater efficacy if proloned antibiotic therapy at least 7-10 days, also was used 3 days therapy.
Tamsulosin was efficacy to reduce prostatic smooth muscle fibers ipertonicit and providing an improved urinary flux, and the Serenoa repens was efficacy with its global effects (antiandrogenic effects, anti-inflammatory effects, pro-apoptotic properties, and relaxation of smooth muscles in the prostate and detrusor).
Boswellia resin extract and propolis derived polyphenols (suppository) was efficacy after 3 days of therapy and more.
See the efficacy of a suppository therapy in control the irritative symptoms in patients undergoing thulium laser enucleation of prostate: as reported in a phase III trial (Bertolo R et al)
Saccaromices cerevisiae supp provide normalization of the situation related the weak emorroides and Fenolmicin P3 e Boisexil supp on the prostatitis (inflamation and pain): in every way improved urinary flux.
(Antimicrobial and antimycotic topic activity, anti inflammatory and antipain if prolonged reduce pain, edema and inflamation).
Related other factors: Because the prostate gland produces fluid for semen an infrequent ejaculation may cause the ducts to become clogged with secretions.
In this case report after ejaculation generally the prostate pain reduced by the emptying process (the global volume of the prostate reduces and reduced prostate capsule tension and smooth muscle fiber): the urinary flux after was better.
It is relevant to consider that into the composition of the semen there are prostaglandin (that show proinflammatory effects).
The name prostaglandin PG derives from the prostate gland, chosen when prostaglandin was first isolated from seminal fluid in 1935 by Ulf von Euler, and Maurice Walter Goldblatt (1895–1967). The frequency of ejaculation can influence Prostatitis frequency rate and also effect on Prostatic cancer PC development.
Of interest the so-called Toxic theory of hyperplastic prostate. (Roger W. Barnes)
Prostaglandin PGE are characterized by proinflammatory activity, contractions of smoot muscle fiber, vasodilatation and regulation of lymphocyte T cell.
CONCLUSION
Even if prostatitis and hemorroides are different pathological event (interesting a gland the first end vessels the second) it is of interest the anatomic proximity (and by their lymphatic and vascular vases)
Various literature report that Intestinal bacteria can enter the prostate through the urinary tract or travel through the bloodstream.
Between the various pharmacological and phytotherapy treatments. In this vicious circle it is of interest to observe the effect played by the Saccaromyces cerevisiae extract as antinflamatory, antimicrobial similar effect, and its property to preserve the epithelial barrier integrity.
The mechanism of action of the Saccaromyces cerevisiae extract is different form a classic antibiotic and not produce antimicrobial resistance or related toxicity and can be used to treat little anal ragades.
It is possible to say that this yeast shows an antagonism effect vs other bacterium.
Other relevant aspects to be taken in consideration
The Prostaglandin (PGE) into the semen liquid and the effect played if not regular sexual activity: PGE is responsible for inflammatory effects, vasodilatation, vases permeability, contraction of the smooth muscle fibre and related the Lymphocyte T regulation: the regularity in sexual activity plays a crucial role to avoid unsuseful inflamation.
The behaviour habits like prolonged sitting into an rigid chair can be responsible of the prostate congestion and also the constipation must to be avoided (using diet fibers, hydration, physical exercise)
Good bowel habits is fundamental. To be considered also stool softeners, osmotic, lubricants stimulants if needed.
Enemas or suppository under physicians’ prescription, if necessary, can help in reducing the congestion.
(Pay attention to sensibilization if prolonged use)
Pelvic muscle training can reduce constipation.
The proctological consultation must to be added to the Urologist examination in order to verify presence or absence of hemorroides or anal fixture that can contribute in the prostatitis development.
While prostatitis does not directly cause the hemorrhoids, an indirect connection exists through factors like the lifestyle habits.
Obviously to treat an acute or recurrent prostatitis is a physicians role but to stop a dangerous vicious circle is also crucial in some kinds of patients with patient direct involving.
It is clear that it must to be followed the registered indication of the topical drugs used in some conditions to be added to systemic therapy but it is also of interest to observe the mechanism of action of the various remedy available.
Every time is avoided an antibiotic it is reduced the possibility to increase antimicrobial resistance.
REFERENCES
- Ikeuchi T, Ueno M, Yogi S, Hasegawa K, Sasaki H, Hamashima T. [Clinical studies on chronic prostatitis and prostatitis-like syndrome.(5) Evaluation of prostatitis complicated by anal disease]. Hinyokika Kiyo.1991; 37: 1677-1682.
- Brühl P, Hansen H. Anogenital syndrome. Int Urol Nephrol. 1986; 18: 169-173.
- Cao H, Zhang D, Wang P, Wang Y, Shi C, Wu H, et al. Gut microbiome: A novel preventive and therapeutic target for prostatic disease. Front Cell Infect Microbiol. 2024; 14: 1431088.
- 4. Palumbo VD, Tutino R, Messina M, Santarelli M, Nigro C, Lo Secco G, et al. Altered Gut Microbic Flora and Haemorrhoids: Could They Have a Possible Relationship? J Clin Med. 2023; 12: 2198.
- Massot J, Sanchez O, Couchy R, Astoin J, Parodi AL. Bacterio- pharmacological activity of Saccharomyces boulardii in clindamycin- induced colitis in the hamster. Arzneimittelforschung. 1984; 34: 794-797.
- Cheng Shen, Zhan Chen, Wei Zhang, Xinfeng Chen, Bing Zheng,
Chunmei Shi. Preliminary study of the effect of gut microbiota on the development of prostatitis. BMC Med Genomics. 2024.
- Jie Chen, Bo Chen, Bin Lin,Yin Huang, Jinze Li, Jin Li, et al. The role of gut microbiota in prostate inflammation and benign prostatic hyperplasia and its therapeutic implications. Heliyon. 2024; e38302.
- uang R, Liu Y, Li B, Wang R, Tamalunas A, Waidelich R, et al. Inhibition of human prostate smooth muscle contraction by the inhibitors of protein kinase C, GF109203X, and Go6983. Prostate. 2022; 82: 59-77.
- Hatoum R, Labrie S, Fliss I. Antimicrobial and probiotic properties of yeasts: from fundamental to novel applications. Front Microbiol. 2012; 3: 421.
- Bayraktar Z, Hacer Inan E, Bayraktar V. Effect of constipation on serum total prostate-specific antigen levels in men. Int J Urol. 2011; 19: 54-59.
- Liao CH, Lin HC, Huang CY. Chronic Prostatitis/Chronic Pelvic Pain Syndrome is associated with Irritable Bowel Syndrome: A Population- based Study. Sci Rep. 2016; 6: 26939.
- 12) Mélanie Deschasaux, Camille Pouchieu, Mathilde His, Serge Hercberg, Paule Latino-Martel, Mathilde Touvier. Dietary Total and Insoluble Fiber Intakes Are Inversely Associated with Prostate Cancer Risk 1, 2, 3. 2014; 144: 504-510.
- Bozzini G, Provenzano M, Buffi N, Seveso M, Lughezzani G, Guazzoni G, et al. An observational study of the use of beclomethasone dipropionate suppositories in the treatment of lower urinary tract inflammation in men. BMC Urol. 2016; 16: 25.
- Mattia Sibona, Paolo Destefanis, Marco Agnello, Beatrice Lillaz, Mattia Giuliano, Tommaso Cai, et al.
- The association of Boswellia resin extract and propolis derived polyphenols can improve quality of life in patients affected by prostatitis-like symptoms. 2019; 91: 251-255.
- Rider JR, Wilson KM, Sinnott JA, Kelly RS, Mucci LA, Giovannucci EL. Ejaculation Frequency and Risk of Prostate Cancer: Updated Results with an Additional Decade of Follow-up. Eur Urol. 2016; 70: 974-982.
- Jacobsen SJ, Jacobson DJ, Rohe DE, Girman CJ, Roberts RO, Lieber MM. Frequency of sexual activity and prostatic health: fact or fairy tale? Urology. 2003; 61: 348-353.
- Barnes RW. Toxic Hyperplasia of the Prostate Gland1. J Urol. 1936; 35: 70-74.
- Hoxha M, Barbonetti A, Zappacosta B. Arachidonic Acid Pathways and Male Fertility: A Systematic Review. Int J Mol Sci. 2023; 24: 8207.
- Wautier JL, Wautier MP. Pro- and Anti-Inflammatory Prostaglandins and Cytokines in Humans: A Mini Review. Int J Mol Sci. 2023; 24: 9647.
- Nakanishi M, Rosenberg DW. Multifaceted roles of PGE2 in inflammation and cancer. Semin Immunopathol. 2013; 35: 123-137.
- Ren J, Karpinski E, Benishin CG. Prostaglandin E2 contracts vascular smooth muscle and inhibits potassium currents in vascular smooth muscle cells of rat tail artery. J Pharmacol Exp Ther. 1995; 275: 710- 719.
- Omori K, Kida T, Hori M, Ozaki H, Murata T. Multiple roles of the PGE2-EP receptor signal in vascular permeability. Br J Pharmacol. 2014; 171: 4879-4889.
- Pavone C, Caldarera E, Liberti P, Miceli V, Di Trapani D Serretta V, et al. Correlation between chronic prostatitis syndrome and pelvic venous disease. A survey of 2554 urologic outpatients. EUROPEAN UROLOGY. 2000; 37: 400-403.
- keuchi T, Ueno M, Yogi S, Hasegawa K, Sasaki H, Hamashima T. [Clinical studies on chronic prostatitis and prostatitis-like syndrome.(5) Evaluation of prostatitis complicated by anal disease]. Hinyokika Kiyo. 1991; 37: 1677-1682.
- Katongole P, Sande OJ, Joloba M, Reynolds SJ, Niyonzima N. The human microbiome and its link in prostate cancer risk and pathogenesis. Infect Agent Cancer. 2020; 15: 53.
- Franco JV, Trivisonno LF, Sgarbossa N, Alvez GA, Fieiras C, Escobar Liquitay CM, et al. Serenoa repens for the Treatment of Lower Urinary Tract Symptoms Due to Benign Prostatic Enlargement: An Updated Cochrane Review. World J Mens Health. 2024; 42: 518-530.
- Dunn CJ, Matheson A, Faulds DM. Tamsulosin: A review of its pharmacology and therapeutic efficacy in the management of lower urinary tract symptoms. Drugs Aging. 2002; 19: 135-161.
- Justia Patents Anal, Rectal (e.g., Suppositories, Etc.)U.S. Patent Application for Method, composition, and delivery mode for treatment of prostatitis and other urogenital infections using a probiotic rectal suppository Patent Application (Application #20080274162)
- Bertolo R, Cipriani C, Vittori M, Carilli M, Maiorino F, Iacovelli V, et al. The efficacy of a suppository based on Phenolmicin P3 and Bosexil (Mictalase®) in control of irritative symptoms in patients undergoing thulium laser enucleation of prostate: a single-center, randomized, controlled, open label, phase III study. BMC Urol. 2022; 22: 19.